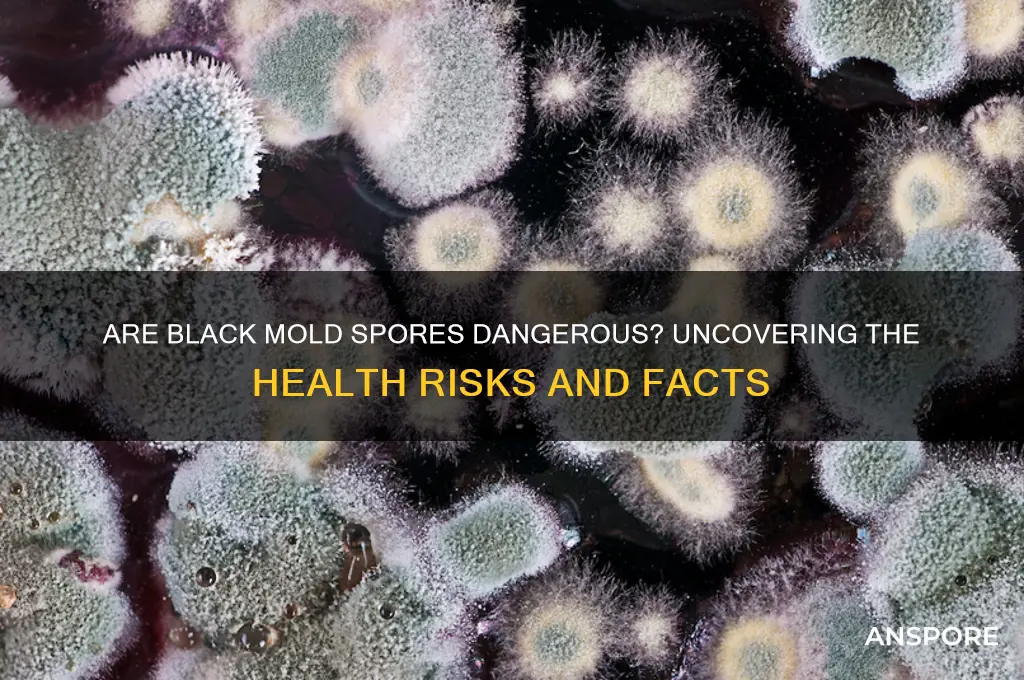
are black mold spores dangerous

Black mold, scientifically known as *Stachybotrys chartarum*, is a type of fungus that thrives in damp, humid environments and is often associated with water-damaged buildings. Its spores, when released into the air, can pose significant health risks, particularly to individuals with compromised immune systems, respiratory conditions, or allergies. Exposure to black mold spores has been linked to symptoms such as coughing, sneezing, skin irritation, and more severe reactions like chronic sinus infections or exacerbation of asthma. Prolonged or intense exposure may even lead to more serious health issues, including mycotoxin-related illnesses. Understanding the dangers of black mold spores is crucial for taking preventive measures, such as improving ventilation, reducing moisture, and promptly addressing mold growth to safeguard health and well-being.
| Characteristics | Values |
|---|---|
| Toxicity | Black mold spores themselves are not toxic, but certain species (e.g., Stachybotrys chartarum) produce mycotoxins that can be harmful when inhaled or ingested. |
| Health Risks | Exposure can cause allergic reactions (sneezing, itching), respiratory issues (asthma, coughing), and in severe cases, neurological symptoms or immune system suppression, especially in sensitive individuals. |
| Vulnerability | Children, the elderly, and immunocompromised individuals are at higher risk of severe health effects from black mold exposure. |
| Common Locations | Thrives in damp, humid environments like basements, bathrooms, and areas with water damage. |
| Prevention | Reduce humidity levels (<50%), fix leaks promptly, and ensure proper ventilation to prevent mold growth. |
| Remediation | Small areas (<10 sq. ft.) can be cleaned with detergent and water; larger infestations require professional removal to avoid spore dispersal. |
| Long-Term Effects | Prolonged exposure may lead to chronic respiratory conditions or other health complications. |
| Detection | Visible black or dark green patches, musty odor, or professional testing (air or surface samples) can confirm presence. |
Explore related products
What You'll Learn

Health risks of inhaling black mold spores
Inhaling black mold spores can trigger a cascade of health issues, particularly for individuals with pre-existing respiratory conditions or weakened immune systems. Stachybotrys chartarum, the scientific name for black mold, releases spores that, when inhaled, can irritate the lungs and airways. For healthy adults, short-term exposure may cause mild symptoms like sneezing, coughing, or a runny nose. However, prolonged or high-level exposure can lead to more severe reactions, including chronic sinus infections, bronchitis, or even fungal pneumonia. Children, the elderly, and those with asthma or allergies are especially vulnerable, as their immune systems are less equipped to handle the toxins produced by black mold.
Consider the case of a family living in a water-damaged home, where black mold proliferated unnoticed behind walls. The parents, both in their 30s, experienced persistent headaches and fatigue, while their 5-year-old child developed recurrent respiratory infections. After testing revealed high levels of black mold spores in the air, remediation efforts significantly improved their symptoms. This example underscores the importance of early detection and intervention. If you suspect mold in your home, use a mold test kit or hire a professional inspector. Addressing moisture issues promptly—fixing leaks, reducing humidity below 50%, and improving ventilation—can prevent mold growth and protect your health.
From a comparative perspective, black mold spores are not inherently more toxic than other mold types, but their mycotoxins can cause more severe reactions in sensitive individuals. For instance, while *Aspergillus* molds are common and often harmless, black mold’s mycotoxins can lead to systemic inflammation or even neurological symptoms in rare cases. Research suggests that inhaling as few as 10,000 spores per cubic meter of air can trigger symptoms in susceptible individuals, though the exact threshold varies based on personal health and exposure duration. To minimize risk, use N95 masks during cleanup and ensure proper ventilation to disperse spores.
Persuasively, ignoring the health risks of black mold spores is akin to neglecting a ticking time bomb in your home. Even if symptoms seem minor at first, cumulative exposure can lead to long-term health complications. For instance, a study published in *Applied and Environmental Microbiology* found that prolonged exposure to black mold spores correlated with decreased lung function in asthmatic children. Practical steps include regularly inspecting areas prone to moisture, such as basements, bathrooms, and kitchens, and using dehumidifiers in damp spaces. If mold is present, avoid disturbing it without protection, as this can release more spores into the air.
Finally, understanding the health risks of inhaling black mold spores empowers you to take proactive measures. For those with severe reactions, consulting a healthcare provider is crucial, as antifungal medications or allergy treatments may be necessary. In workplaces or schools with mold issues, advocate for remediation to protect collective health. Remember, prevention is key: small actions like wiping down shower walls weekly or using exhaust fans during cooking can significantly reduce mold growth. By staying informed and vigilant, you can safeguard yourself and your loved ones from the hidden dangers of black mold spores.
Discover the Best Platforms to Play Spore: A Comprehensive Guide
You may want to see also

Symptoms of black mold exposure in humans
Black mold, scientifically known as *Stachybotrys chartarum*, produces spores that can trigger a range of health issues when inhaled or touched. While not everyone reacts the same way, prolonged or intense exposure increases the risk of symptoms. The severity depends on factors like the duration of exposure, the concentration of spores, and individual sensitivity, particularly in children, the elderly, and those with compromised immune systems.
Respiratory Distress: The Immediate Red Flag
Inhaling black mold spores often leads to respiratory symptoms, mimicking allergies or asthma. Common signs include persistent coughing, wheezing, nasal congestion, and throat irritation. For asthmatics, exposure can exacerbate flare-ups, requiring increased use of inhalers. A 2004 Institute of Medicine report linked indoor mold exposure to respiratory issues, emphasizing the need for prompt action if these symptoms arise in damp environments.
Skin and Eye Irritation: Visible Warning Signs
Direct contact with mold-infested surfaces or airborne spores can cause skin and eye irritation. Redness, itching, or a rash may develop upon touching contaminated materials, while eyes may become watery, itchy, or inflamed. These reactions are typically localized and resolve once exposure ceases, but they serve as a clear indicator of mold presence.
Systemic Symptoms: When Mold Affects More Than the Surface
Prolonged exposure, especially in sensitive individuals, can lead to systemic symptoms like headaches, fatigue, and dizziness. While less common, these effects highlight the body’s broader response to mycotoxins, toxic substances produced by certain molds. Children and those with pre-existing conditions are more susceptible, making it crucial to monitor for persistent or worsening symptoms.
Prevention and Action: Practical Steps to Mitigate Risk
To minimize exposure, maintain indoor humidity below 50%, promptly fix leaks, and ensure proper ventilation in bathrooms and kitchens. If symptoms occur, remove yourself from the environment and consult a healthcare provider. For confirmed mold infestations, professional remediation is often necessary to eliminate the source and prevent recurrence. Early detection and intervention are key to avoiding long-term health complications.
Understanding Mold Spore Size: Invisible Threats and Their Impact
You may want to see also

Black mold toxicity levels and dangers
Black mold, scientifically known as *Stachybotrys chartarum*, produces mycotoxins that can pose serious health risks when inhaled, ingested, or touched. The toxicity level depends on the concentration of spores and the duration of exposure. For instance, short-term exposure to low levels may cause mild symptoms like sneezing or skin irritation, while prolonged exposure to high concentrations can lead to severe respiratory issues, neurological problems, or even systemic inflammation. Vulnerable populations, such as children, the elderly, and individuals with compromised immune systems, are at greater risk due to their reduced ability to detoxify these harmful substances.
Understanding the dangers of black mold requires recognizing its insidious nature. Unlike immediate toxins, the effects of black mold often manifest gradually, making it difficult to pinpoint the cause of symptoms. For example, chronic exposure in damp environments can lead to conditions like hypersensitivity pneumonitis, a lung inflammation that mimics pneumonia. Studies have shown that mycotoxins from black mold can also disrupt the body’s natural immune response, exacerbating allergies or asthma. Practical precautions include maintaining indoor humidity below 50%, promptly fixing water leaks, and using HEPA filters to reduce airborne spore counts.
A comparative analysis of black mold toxicity reveals that its dangers are not uniform across all strains or environments. While *Stachybotrys chartarum* is notorious for producing trichothecene mycotoxins, other molds like *Aspergillus* or *Penicillium* can also release harmful substances. However, black mold’s toxicity is particularly concerning due to its ability to thrive in water-damaged buildings and release spores that remain viable for extended periods. Unlike surface molds that are easily removable, black mold often grows within walls or under flooring, requiring professional remediation to eliminate completely.
To mitigate the risks of black mold toxicity, follow these actionable steps: First, inspect areas prone to moisture, such as basements, bathrooms, and attics, for visible mold growth or musty odors. Second, use protective gear like gloves, masks, and goggles when cleaning moldy surfaces to avoid direct contact with spores. Third, for extensive infestations, hire certified mold remediation specialists to ensure thorough removal. Lastly, monitor indoor air quality with mold testing kits, especially after water damage incidents. By taking proactive measures, you can significantly reduce the health risks associated with black mold exposure.
Can Vinegar Effectively Eliminate Airborne Mold Spores? Facts Revealed
You may want to see also
Explore related products

Preventing black mold growth in homes
Black mold spores are a silent invader, thriving in damp, dark corners of homes and posing serious health risks. Preventing their growth is not just about aesthetics; it’s about safeguarding your family’s well-being. Mold spores are ubiquitous, but they only become a problem when they find the right conditions to multiply. Understanding these conditions is the first step in keeping your home mold-free.
Control Moisture, Control Mold
Mold needs moisture to grow, making humidity its best friend. Keep indoor humidity below 60% using dehumidifiers, especially in basements, bathrooms, and kitchens. Fix leaks immediately—even small drips under sinks or around windows can create breeding grounds for mold. After showers, wipe down wet surfaces and use exhaust fans to expel damp air. Regularly inspect areas prone to condensation, like pipes and windowsills, and insulate them to prevent moisture buildup.
Ventilation: The Unsung Hero
Stagnant air traps moisture, creating an ideal environment for mold. Improve airflow by opening windows, using fans, and ensuring vents are unobstructed. In areas like laundry rooms or kitchens, where moisture is generated frequently, proper ventilation is non-negotiable. Consider installing a vent fan if your space lacks one. Even in colder months, allow fresh air to circulate briefly to reduce humidity levels.
Material Matters: Choose Wisely
Certain materials are more mold-resistant than others. Opt for mold-resistant drywall in basements or bathrooms, and use semi-gloss or satin paint, which resists moisture better than flat paint. Avoid carpeting in damp areas; instead, choose tile, hardwood, or mold-resistant flooring. If you already have carpets, clean them regularly and ensure they dry completely after cleaning to prevent spore settlement.
Routine Inspections: Catch It Early
Mold often grows unnoticed until it becomes a major problem. Conduct monthly inspections of hidden areas like behind appliances, under sinks, and inside closets. Look for telltale signs: musty odors, discolored walls, or warped surfaces. If you spot mold, address it promptly. For small areas (less than 10 square feet), scrub with a mixture of water and detergent, then dry thoroughly. For larger infestations, consult professionals to avoid spreading spores.
By taking proactive steps to control moisture, improve ventilation, choose the right materials, and inspect regularly, you can prevent black mold growth and protect your home from its dangers. Remember, mold prevention is an ongoing process, not a one-time task. Stay vigilant, and your home will remain a healthy haven.
Are Spore Servers Still Active in 2023? A Comprehensive Update
You may want to see also

Long-term effects of black mold exposure
Black mold, scientifically known as *Stachybotrys chartarum*, produces spores that can have serious health implications when inhaled or touched over extended periods. While short-term exposure may cause mild symptoms like sneezing or skin irritation, long-term exposure can lead to chronic health issues, particularly in vulnerable populations such as children, the elderly, and individuals with compromised immune systems. Understanding these effects is crucial for prevention and early intervention.
One of the most concerning long-term effects of black mold exposure is its impact on respiratory health. Prolonged inhalation of mold spores can exacerbate asthma, leading to more frequent and severe attacks. Studies have shown that individuals living in mold-infested environments are at a higher risk of developing chronic obstructive pulmonary disease (COPD) or other persistent respiratory conditions. For children, repeated exposure during developmental years can impair lung function permanently, making early detection and remediation essential. Practical steps include using air purifiers with HEPA filters and regularly inspecting damp areas like basements and bathrooms for mold growth.
Another significant long-term effect is the potential for neurological damage. Mycotoxins produced by black mold can cross the blood-brain barrier, causing symptoms such as memory loss, headaches, and even mood disorders like anxiety or depression. While research is still evolving, case studies have linked prolonged mold exposure to cognitive decline in adults. To mitigate this risk, ensure proper ventilation in homes, especially in areas prone to moisture buildup, and address leaks or water damage immediately.
Long-term exposure to black mold can also weaken the immune system, making the body more susceptible to infections and illnesses. This is particularly dangerous for individuals with pre-existing conditions or those undergoing immunosuppressive treatments. Over time, the body’s ability to fight off pathogens diminishes, leading to recurrent infections or prolonged recovery times. A proactive approach includes monitoring indoor humidity levels (ideally below 50%) and using dehumidifiers in high-moisture areas.
Finally, the psychological toll of living in a mold-contaminated environment cannot be overlooked. Chronic exposure has been associated with increased stress, fatigue, and a reduced quality of life. The persistent nature of mold-related symptoms can lead to feelings of helplessness or frustration, particularly if the source of contamination is not identified and addressed. Seeking professional mold remediation services and consulting healthcare providers for symptom management are critical steps in breaking this cycle. By addressing both the physical and mental health impacts, individuals can protect themselves from the far-reaching consequences of long-term black mold exposure.
Are Psilocybe Spores Legal? Exploring the Legal Landscape and Implications
You may want to see also
Frequently asked questions
Black mold spores can be dangerous, particularly to individuals with compromised immune systems, respiratory conditions, allergies, or asthma. Healthy individuals may experience mild symptoms or none at all.
Exposure to black mold spores can cause respiratory issues, allergic reactions (sneezing, itching, watery eyes), headaches, fatigue, and in severe cases, fungal infections in immunocompromised individuals.
Prolonged exposure to black mold spores may contribute to chronic respiratory problems, persistent allergies, and in rare cases, conditions like hypersensitivity pneumonitis or toxic mold syndrome.
Black mold spores spread through the air, attaching to surfaces, clothing, or pets. They thrive in damp, humid environments and can quickly colonize if moisture issues are not addressed.
If you find black mold spores, address the moisture source, improve ventilation, and clean small areas with mold-killing solutions. For large infestations, consult a professional mold remediation service.































